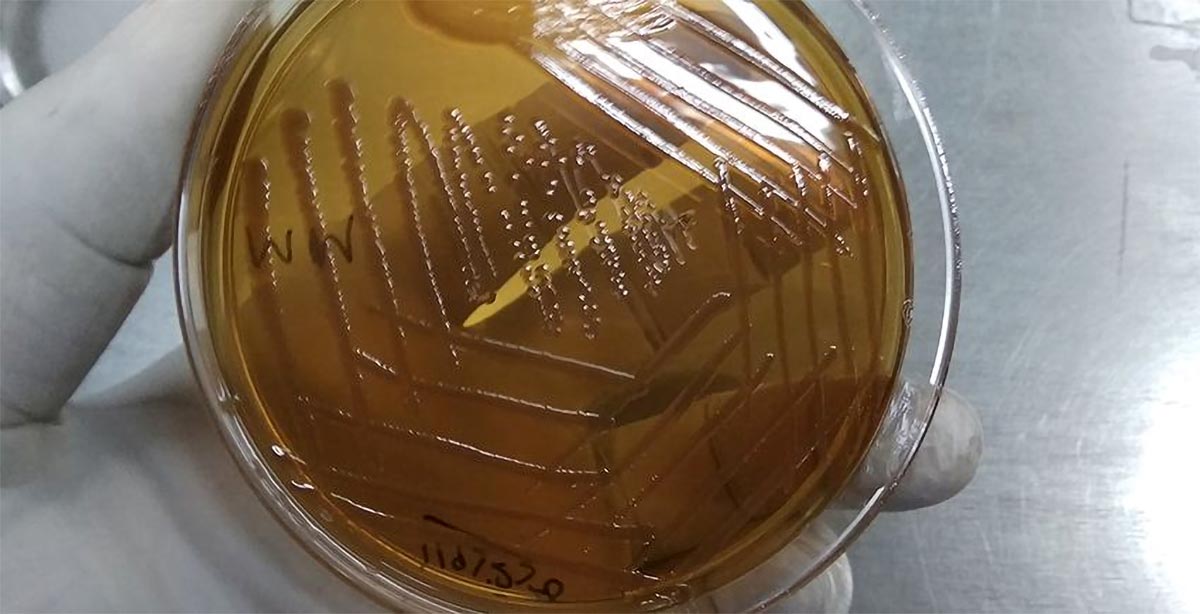
scitechdaily.com

S
Salino438
Silver
- Joined
- Oct 6, 2019
- Posts
- 697
- Reputation
- 673
- OP
- #151

Giving up sugar can change your body for the better—within days
Reducing sugar intake can provide many surprising health benefits—from better skin to a lower risk of diabetes. “We’re talking potential improvements within days or weeks, not months or years.”